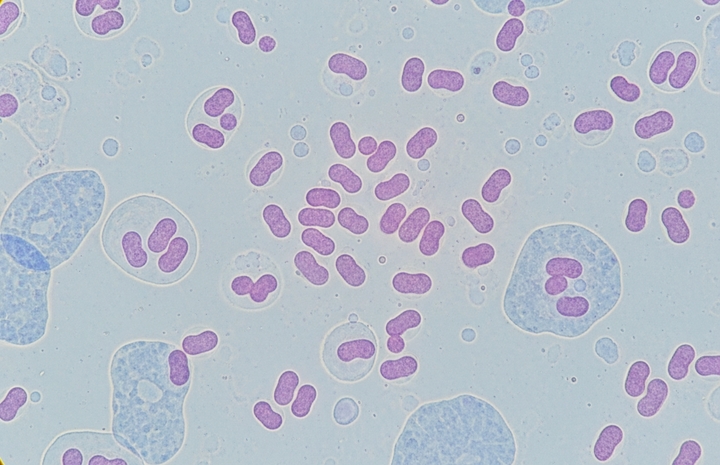
Hà Nội ghi nhận ca mắc não mô cầu là trẻ 11 tuổi, chưa tiêm vaccine

Tôi xem phim Sex Education không chỉ vì tò mò về bộ phim nổi tiếng, mà vì thật sự ấn tượng với cách phim khắc họa tâm lý tuổi mới lớn. Có một cảnh khiến tôi xúc động mãi, đó là khi Jean sinh em bé thứ hai, rơi vào tình trạng nguy kịch. Otis, cậu con trai tưởng chừng đã rất "người lớn", đã bật khóc nức nở, thú nhận với mẹ rằng cậu vẫn chỉ là một đứa trẻ và cần có mẹ ở bên. Trước đó, Otis luôn cố tỏ ra trưởng thành, luôn cư xử như người hiểu chuyện, tự cho rằng mình không cần mẹ can thiệp vào cuộc sống.
Nhìn cảnh ấy, tôi chợt thấy bóng dáng con gái mình. Con bé năm nay học lớp 9, cũng đang trong giai đoạn "ẩm ương", nửa trẻ con, nửa người lớn. Con rất hay gắt gỏng, hay cãi lại mẹ. Chỉ cần tôi góp ý điều gì, con lập tức phản ứng: "Mẹ đừng lo cho con nữa, con biết rồi." Nhiều khi tôi vừa buồn, vừa buông xuôi, nghĩ rằng con đang lớn, có lẽ nên để con tự trải nghiệm.
Cho đến một ngày, tôi mới nhận ra, hóa ra "người lớn" của con chỉ là vẻ ngoài. Hôm đó, cô giáo chủ nhiệm gọi điện cho tôi, nói rằng gần đây con trông buồn và lặng lẽ. Tôi hỏi thì con chỉ nói "Không có gì". Sau này tôi mới biết, con bị một nhóm bạn trong lớp bắt nạt. Khi tôi gặng hỏi, con gắt lên:
- Mẹ đừng xen vào! Con tự giải quyết được!
Tôi đành lặng im, tôn trọng mong muốn của con.

Phim Sex Education
Nhưng rồi một buổi tối, con về nhà, vừa bước vào cửa đã òa khóc. Con run run kể rằng nhóm bạn kia đã ghép ảnh linh tinh, rồi đăng lên mạng xã hội. Bạn bè trong lớp xì xào, chỉ trỏ khiến con hoảng loạn và xấu hổ. Con nấc lên:
- Mẹ ơi, mẹ giúp con với... Con không biết phải làm sao.
Lúc ấy, lòng tôi thắt lại. Tôi vừa thương vừa giận, nhưng chỉ ôm con và nói:
- Không sao đâu, con ạ. Con vẫn còn nhỏ, và bố mẹ vẫn luôn ở đây để bảo vệ con. Con nhờ mẹ giúp, điều đó không có gì xấu cả.
Sau đó, tôi nói chuyện với giáo viên chủ nhiệm và phụ huynh các bạn liên quan. Mọi chuyện được giải quyết ổn thỏa. Nhưng điều khiến tôi nhớ mãi là hình ảnh con bé ôm tôi, khóc ướt vai, nói lí nhí:
- Con tưởng con mạnh mẽ hơn cơ...
Tôi mỉm cười. Trong khoảnh khắc ấy, tôi thấy con vẫn là đứa trẻ mà tôi từng bế ẵm, chỉ là đang tập tành học cách lớn lên.
Bộ phim Sex Education khiến tôi hiểu ra rằng: Trẻ con, dù có cố tỏ ra "người lớn" đến đâu, vẫn cần có bố mẹ làm điểm tựa. Và đôi khi, điều tốt nhất mà cha mẹ có thể làm, chính là cho con biết rằng, dù con có vấp ngã bao nhiêu lần, vẫn luôn có một nơi để quay về, một vòng tay để nương tựa.
Thanh Hương
if (pageSettings.allow3rd) admicroAD.unit.push(function () { admicroAD.show('admzonek1fs4xky') });